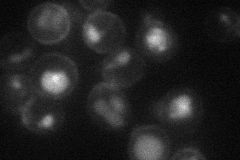
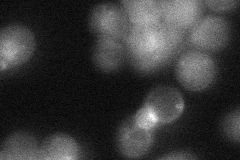

View description
Mannoprotein that exhibits a tight association with the cell wall, required for cell wall stability in the absence of GPI-anchored mannoproteins; has a high serine-threonine content; expression is induced in cell wall mutants
Localization:
Intensity:
Fold change:
Significance:
-
C’ GFP library in SD

cytosol24.91 -
N' NOP1pr-GFP in SD

cell periphery,vacuole65.3924 -
N' TEF2pr-mCherry in SD
cell periphery,vacuole25.4346 -
N' NATIVEpr-GFP in SD
ambiguous,bud26.8618 -
N' TEF2pr-VC and Cyto-VN in SD

#N/A0 -
C’ GFP library in SD+DTT

cytosol21.180.85No -
C’ GFP library in SD+H2O2

cytosol21.070.84No -
C’ GFP library in Starvation Media

cytosol17.450.7No -
C’ GFP library on the background of Pup2-DaMP

cytosol -
C’ GFP library on the background of CCT mutant

cytosol22.79130.91464No
